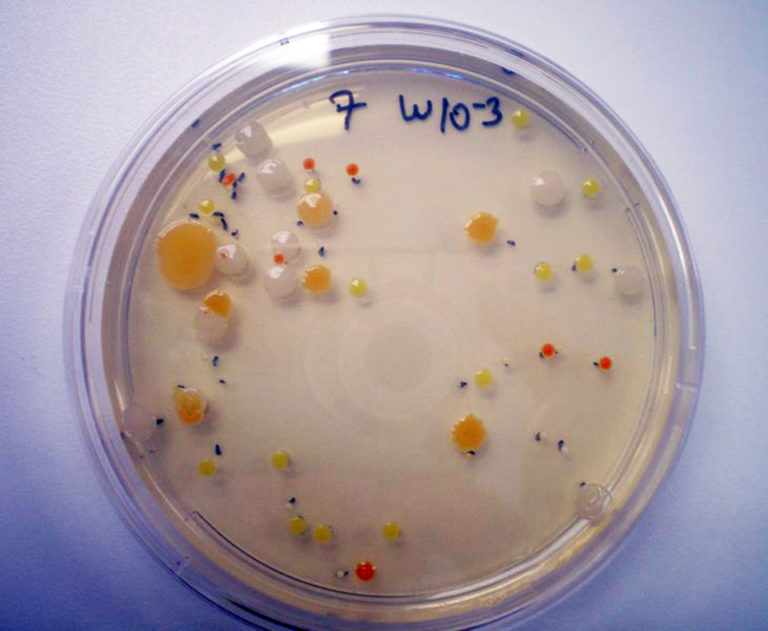

Health & Welfare
Probiotics, prebiotics in aquatic animals
Research has shown that probiotics and prebiotics can help mediate stress responses and improve disease resistance, growth performance, feed utilization, carcass composition and other traits by stimulating animals’ innate immune systems.














